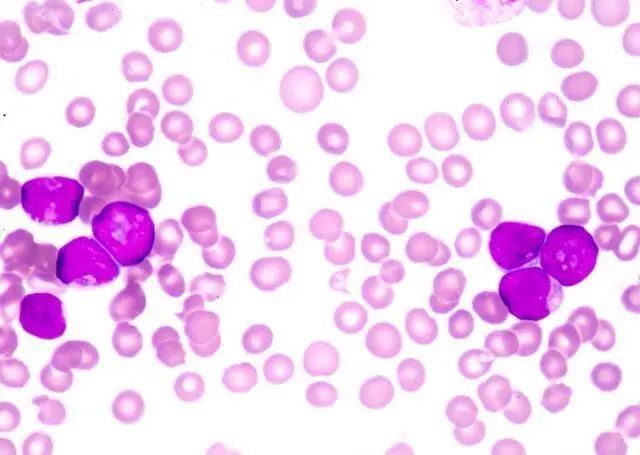

癌字是每个人讳莫如深的字眼,看到后难免心中一惊,最害怕癌症缠身。根据生长部位,癌症又分为 原位癌 和浸润癌,但这让人傻傻并不清楚,既然都是癌症,两者到底有什么区别呢,哪种对身体带的危害最大,不妨一一来解答。

什么是原位癌?
原位癌顾名思义是生长在皮肤或黏膜内的癌变,没有经过皮肤或李季霏黏膜下 基底膜 ,真皮组织没有受到侵犯,也没有出现浸润和远处转移的情况。原位癌常常被称为0期癌或浸润前癌,这并不算真正意义上的癌症。原位癌常见于老年人,易发生在角结膜交界处,肿瘤跟周围正常组织界限较明显。原位癌发展速度极慢,上皮基底膜完整无缺,预后良好。
原位癌和 浸润癌 有什么区别?
原位癌和浸润癌最大的区别是皮肤或黏膜下表层是否被侵犯。随着原位癌进一步发展,适宜的环境下癌细胞会快速增殖,不仅仅穿透基底膜,而且也会侵入皮肤或黏膜下表层,甚至会向周围转移,这是真正意义上的癌症。浸润癌中晚期需通过手术方式切除。然后通过放疗和化疗的方式杀死潜藏的癌细胞,提高生存率。
原位癌有哪些特点?
1、发病率较高
现在人们生活的环境污染较严重,再加上工作和生活压力大,科学技术进一步发展,因此原位癌的发病率逐年升高,特别是发生在乳腺、直肠以及皮肤上的原位癌。
2、缺乏典型症状
通常原位癌几乎没有典型症状,大部分患者体检时才被检查出。
3、预后良好
手术切除是治疗原位癌最好的方法,趁着还没有出现浸润癌,手术切除治愈率能达到9成以上。

原位癌和浸润癌哪个比较严重雷丰企业名录网?
原位癌和浸润癌比较,当然是浸润癌最为严重。原位癌没有转移的特点,算是较轻微的病征,及早通过手术方式切除,不需放疗和化疗就能完全治愈,治疗费用便宜。但浸润癌不同,癌细胞可持续性发展,穿透基底膜,紧阴美易向远处或周围转移,治疗起来较困难,5年生存率较低。
常见的原位癌有哪些?
1、 子宫颈原位癌
宫颈上皮内瘤若一直放任不管可转化为子宫颈抄一份书稿原位癌,癌细胞、大小排列以及形状不一样。引起子宫颈原位癌的因素有很多,如受到 人乳头瘤病毒感染 、房事不洁和滥用药物等。
2、胃部原位癌
一日三餐不规律、背负着沉重的压力、暴饮暴食等易引起慢性胃炎,随着疾病进一步恶化,可发展成胃部原位癌。

3、皮肤原位癌
长期受到太阳光暴晒是引起皮肤原位癌的主要因素,好发于头颈部、躯干或双手。
温馨提示
综合所述,浸润癌的危害性最大。若体检是原位癌,不要太担心,应及早通过手术方式切除。做完手术后定期去医院做筛查,与此同时要做好生活干预,拒绝吸烟喝酒,保持一日三餐规律性,保证有充足睡眠,多运动来预防疾病复发。


